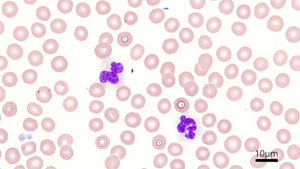

英論文紹介: 赤血球の保存温度と時間
ついこないだ新年が明けて横浜でも先日雪が降ったと思っていたら、時折やたら暖かい日が何日かあったりして。春と共に花粉のおとずれも時折感じる今日この頃ですね。動物たちも寒暖差のせいか原因のはっきりしない胃腸症状の相談をよくいただきますので、皆さま節制した生活を通じて養生されてください。さて、本日も英論文紹介をしていきたいと思います。私が更新している日本獣医輸血研究会のホームページもあわせてご覧ください。
以前、輸血の4時間ルールという70年前から続くいにしえの決まりごとを取り上げたことがありました。その論文では、血漿製剤を輸血する場合、輸血は4時間以内に終わらせなくても、12時間は有効性が確保されていて安全に投与できるという結論で締めくくっていました。今回紹介する論文はその内容と似通った部分があるのですが、今度は犬の保存全血を任意の温度(1、4、10、25、35℃)で24時間静置したら、赤血球膜がダメージを受けて溶血しやすくなってしまうのかを調べています。
少し脱線しますが医学では4時間ルールとは別に輸血の30分ルールと言って、医療機関内で輸血のために出庫された赤血球製剤が30分以上冷蔵されていなかった場合、赤血球の活性や品質を担保できなくなるため、その製剤は在庫に戻してはならないとするルールがあるそうです。つまり、輸血部から持ち出された製剤が室温で30分以上経過した場合、たとえ未使用でも原則破棄となるということです。30分、というのはやや厳しすぎやしないかという印象はありますが、それだけ温度変化に敏感な赤血球なので、筆者たちもそこを調べてくれた訳ですね。
結果、犬の全血製剤を28日以上保存し、かつ25℃以上の温度に少なくとも一定時間以上暴露させると赤血球膜の浸透圧に対する脆弱性が上昇するとしています。よって少なくとも1-10℃で管理出来ていたら30分ルールは気にしなくても割と大丈夫なのでは、という結果です。一方、温度が25℃、35℃の時はいったい何時間静置していたら赤血球膜がダメになってきたのかというのは気になります。研究条件の設定が任意の温度で24時間静置と冗長なので、その途中がどうなのか。
ただ輸血の4時間ルール(4時間以内に投与を終わらせる)の方をあまり気にせず、投与開始からゆっくり半日~夜通し輸血をしているような施設も時折見かけます。少なくとも今回の研究から言えることとして、保存全血を昼夜を徹して輸血していたら、血液バッグ内でどんどん赤血球膜が変性し、折角の輸血の有効性が低下している可能性は危惧されます。適切な輸血方法の遵守を心掛けていきたいところですね。
室温30分静置がだめかどうかは謎に包まれたままですが、冷蔵庫から出した血液が30分とか1時間とかそのままそこにボーっと置かれている状況自体があってはならないような気もします。筆者たちも、今回の研究の背景として血液バンクから各動物病院へ輸送する過程の温度変化なんかを想定していますからね。車で運んでいるときは不測の事態が生じそうで怖いです。でも台湾の研究チームだからか、35℃という温度設定が研究条件の中に組み込まれていて驚きました。さすが熱帯~亜熱帯に位置する国からのデータです。筆者たちが所属する国立屏東大学には台湾初の動物用血液バンクが2016年に完成したみたいで。またいつか台湾に行く機会があったら見学してみたいですねぇ。